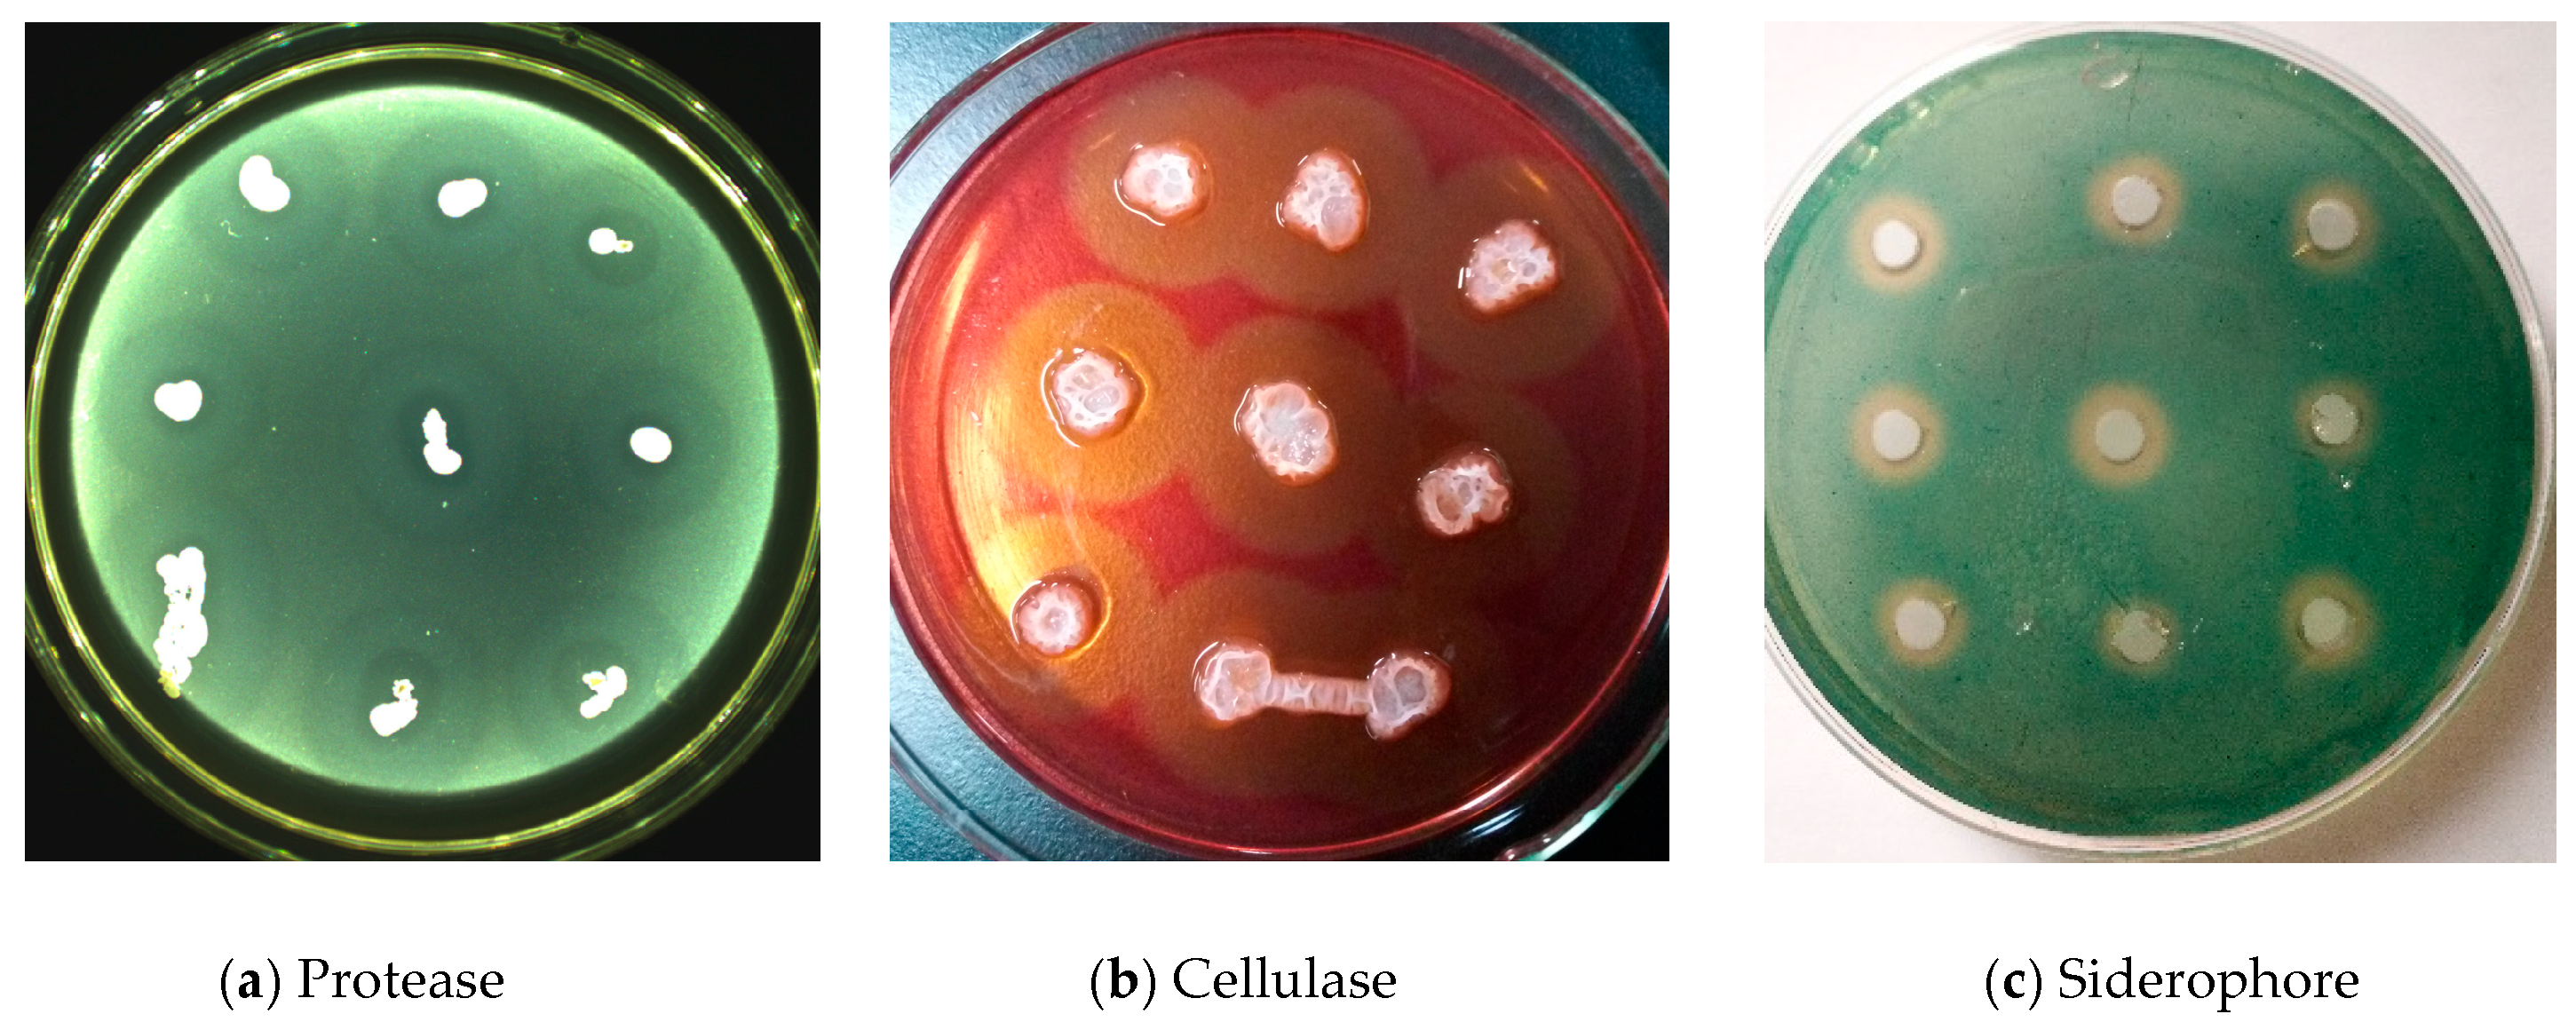
Agronomy 14 01532 g005

New Strain of Bacillus amyloliquefaciens G1 as a Potential Downy Mildew Biocontrol Agent for Grape
Abstract
1. Introduction
2. Materials and Methods
2.1. Materials
2.1.1. Isolation of Bacteria from Stems
2.1.2. Separation of Bacteria from Fruits
2.1.3. Separation of Bacteria from Seeds
2.2. Inhibition of Disease by Endogenous Bacteria
2.2.1. Preparation of Biocontrol Bacterial Suspension
2.2.2. Preparation of Grape Downy Mildew Sporangia
2.3. Determination of Endophytic Antagonistic Bacteria in the Field
2.4. Identification of Endogenous Antagonistic Bacteria
2.4.1. Morphological Analysis
2.4.2. S rDNA Sequence Analysis
2.5. Detection of Activity of Endogenous Antagonistic Enzymes and Secondary Metabolites
2.5.1. Detection of Protease Activity
2.5.2. Cellulase Activity Test
2.5.3. Detection of Siderophore Activity
2.6. Extraction of Antifungal Crude Protein from Antagonistic Strain G1
2.7. Determination of Antibacterial Activity of Protein
Determination of Bacterial Inhibitory Activity Using the Agar Well Diffusion Standoff Method
2.8. Purification and Identification of Strain G1 Antifungal Protein
2.8.1. Q-Sepharose FF Anion Exchange Chromatography
2.8.2. Identification of Proteins by LC-MS
2.9. Data Retrieval
3. Results
3.1. Isolation of Endophytic Bacteria from Grape Tissue
3.2. Endogenous Strains Capable of Inhibiting Downy Mildew
3.3. Effects of Endophytic Antagonistic Strains on Downy Mildew in the Field
3.4. Identification of G1
3.4.1. Morphological Examination
3.4.2. 16S rDNA Sequence Analysis
3.5. Enzyme Activity and Secondary Metabolites of G1
3.6. Antibacterial Activity of Crude Protein from G1
3.6.1. Extraction of Crude Protein
3.6.2. Inhibitory Effects of G1 against Pathogenic Fungi
3.6.3. Effects of G1 on Spore Germination
3.7. Purification and Identification of Antifungal Protein
3.7.1. Q-Sepharose FF Anion Exchange Chromatography
3.7.2. Identification of Proteins by LC-MS
4. Discussion and Conclusions
Author Contributions
Funding
Data Availability Statement
Conflicts of Interest
References
- Du, X.; Li, Z.; Ji, X.; Ran, L. Long-term preservation methods for sporangia of Plasmopara viticola. Acta Bot. Sin. 2008, 27, 908–914. [Google Scholar]
- Wong, F.P.; Burr, H.N.; Wilcox, W.F. Heterothallism in Plasmopara viticola. Plant Pathol. 2001, 50, 427–432. [Google Scholar] [CrossRef]
- Chen, H.; Hu, L.; Tang, C.; Hu, J.; Shi, Z. Efficacy of the strain B-FS01 of Bacillus subtilis in suppression of the grape downy mildew caused by Plasmopara viticola. Plant Prot. 2011, 37, 194–197. [Google Scholar]
- Shi, J.; Yang, Z. Present Situation of The Study on Grapevine Downy Mildew. North Ningxia Agric. Coll. 2004, 25, 92–94. [Google Scholar]
- Sturz, A.V.; Christie, B.R.; Nowak, J. Bacterial endophytes: Potential role in developing sustainable systems of crop production. Crit. Rev. Plant Sci. 2000, 19, 1–30. [Google Scholar] [CrossRef]
- Jalgaonwala, R.E.; Mahajan, R.T. A review: Bacterial endophytes and their bioprospecting. J. Pharm. Res. 2011, 4, 795–799. [Google Scholar]
- Wang, F.; Chao, S.H.; Tsai, C.H.; Blanco, S.D.; Yang, Y.Y.; Lin, Y.H. Developing fermentation liquid of Bacillus amyloliquefaciens PMB04 to control bacterial leaf spot of sweet pepper. Agriculture 2023, 13, 1456. [Google Scholar] [CrossRef]
- Zhang, D.; Huang, K.; Ye, C.; Zou, D.; Liu, D.; Wei, X. Enhancing biological control of apple rot: Unveiling the antifungal potential and mechanism of Bacillus amyloliquefaciens HZ-12′s lipopeptide. Sci. Hortic. 2024, 325, 112704. [Google Scholar] [CrossRef]
- Williamson, B.; Tudzynski, B.; Tudzynski, P.; Van Kan, J. Botrytis cinerea: The cause of grey mould disease. Mol. Plant Pathol. 2007, 8, 561–580. [Google Scholar] [CrossRef]
- Bois, B.; Zito, S.; Calonnec, A. Climate vs grapevine pests and diseases worldwide: The first results of a global survey. OENO One 2017, 51, 133–139. [Google Scholar] [CrossRef]
- Li, W. Screening and Control Effect of Antagonists and Antibiotics on Grapevine Downy Mildew. Master’s Thesis, Hebei Agricultural University, Baoding, China, 2015. [Google Scholar]
- Xu, J.; Zhang, S.; Zhan, H.; Pu, Z. Research on the control of grape mildew by compounding potassium phosphite containing amino acid and manganese zinc diclofenac. Zhejiang Citrus 2020, 37, 29–32. [Google Scholar]
- Wang, Y. Biocontrol of Wheat Leaf Rust Caused by Puccinia triticina and Induction of Systemic Acquired Resistance by Salicylic Acid. Master’s Thesis, Hebei Agricultural University, Baoding, China, 2011. [Google Scholar]
- Ghose, T.K. Measurement of cellulase activities. Int. Union Pure Appl. Chem. 1987, 59, 257–268. [Google Scholar] [CrossRef]
- Shin, S.H.; Lim, Y.; Lee, S.E.; Yang, N.W.; Rhee, J.H. CAS agar diffusion assay for the measurement of siderophores in biological fluids. J. Microbiol. Methods 2001, 44, 89–95. [Google Scholar] [CrossRef] [PubMed]
- Li, T.; Long, M. Study on Bacillus amyloliquefaciens B10 Inhibiting Cloning and Expression of Growth Active Substance of Aspergillusflavus and its Efficacy. Anim. Nutr. 2023, 35, 8024–8035. [Google Scholar]
- Chen, L.H.; Zhang, A.X.; Zhu, T.; Lai, Z.B.; Wang, Z.H.; Chen, H.G. Identification and characterization of bacteria antagonistic to Rhizoctonia cerealis. Chin. J. Plant Pathol. 2008, 38, 88–95. [Google Scholar]
- Kamensky, M.; Ovadis, M.; Chet, I.; Chernin, L. Soil-borne strain IC14 of Serratia plymuthica with multiple mechanisms of antifungal activity provides biocontrol of Botrytis cinerea and Sclerotinia sclerotiorum diseases. Soil Biol. Biochem. 2003, 35, 323–331. [Google Scholar] [CrossRef]
- Xue, Q.Y.; Li, J.Q.; Zheng, Y.; Ding, X.Y.; Guo, J.H. Screening tomato-associated bacteria for biological control of grey mold on tomato. Biocontrol Sci. Technol. 2013, 23, 245–259. [Google Scholar] [CrossRef]
- Arora, N.K.; Kim, M.J.; Kang, S.C.; Maheshwari, D.K. Role of chitinase and β-1,3-glucanase activities produced by a fluorescent pseudomonad and in vitro inhibition of Phytophthora capsici and Rhizoctonia solani. Can. J. Microbiol. 2007, 53, 207–212. [Google Scholar] [CrossRef] [PubMed]
- Picard, K.; Tirilly, Y.; Benhamou, N. Cytological effects of cellulases in the parasitism of Phytophthora parasitica by Pythium oligandrum. Appl. Environ. Microbiol. 2000, 66, 4305–4314. [Google Scholar] [CrossRef]
- Zang, C.; Zhao, K.; Liu, C.; Liang, C.; Liu, L.; Yu, S. Inhibitory Effect of SY286 Strain against Plasmopara viticola. J. Shenyang Agric. Univ. 2014, 45, 221–224. [Google Scholar]
- Cheng, Z.; Zhang, H.; Zhang, N.; Qiao, Y. Physicochemical property and inhibitory activity against Penicillium digitatum of antifungal crude protein produced by Bacillus am yloliquefaciens RY3. Food Mach. 2013, 29, 187–190. [Google Scholar]
- Zhang, B.; Zhang, J.; Han, J.; Liu, H.; Wang, J. Purification and characterization of an antifungal protein from endophytic Bacillus amyloliquefaciens LP-5. Chin. J. Plant Prot. 2010, 37, 143–147. [Google Scholar]
- Zheng, X.; Dong, C.; Niu, R.; Qi, X.; Sun, C.; Wang, X.; Liu, C.; Jia, G.; Chen, Z. Characterization and inhibition effects of antifungal protein from Bacillus subtilis Zl-2. J. Nat. Sci. Heilongjiang Univ. 2018, 35, 206–211. [Google Scholar]
- Yang, W. Preliminary Study on the Antimicrobial Protein Of The Bioprophylactic Bacillus cereus S3-1 and Optimization of the Fermentation Process. Master’s Thesis, Shanghai Normal University, Shanghai, China, 2021. [Google Scholar]
- Hu, J.; Wu, Y.; Li, J.; Wei, Y.; Chen, Q.; Yang, H. Study on the control effect of antagonistic Bacillus polymyxa bacillus PB-2 and its preparation on grape downy mildew. Shandong Sci. 2014, 27, 30–33. [Google Scholar]
- Xie, X.; Wang, Y.; Hu, J.; Yang, H.; Li, J. Screening and identification of antagonistic bacteria strain BMJBN02 and its effect on grape downy mildew. Shandong Sci. 2015, 28, 39–44, 73. [Google Scholar]
- Zhu, L.; Wu, X.; Chen, T.; Xu, X. Elementary Properties of the Nematicidal Crude Toxin Produced by Bacillus amyloliquefaciens JK-JS3. Chin. J. Biol. Control 2009, 25, 359–363. [Google Scholar]
- Tian, J.; Wang, Y.; Zhang, S. Field control efficacy of Bacillus amyloliquefaciens on rice bakanae disease. Heilongjiang Sci. 2010, 1, 10–11, 14. [Google Scholar]
- Arrebola, E.; Sivakumar, D.; Korsten, L. Effect of volatile compounds produced by Bacillus strains on postharvest decay in citrus. Biol. Control 2010, 53, 122–128. [Google Scholar] [CrossRef]
- Lu, J.; Xia, Q.; Gu, W. Isolation, identification of Bacillus amyloliquefaciens LX1 Strain Againsts Fusarium oxysporum f. sp. cubense and cloning of its antifungal protein gene. Acta Metall. Sin. 2013, 34, 117–124. [Google Scholar]
- Santhosh, C.R.; Mahadevakuamar, S.; Nuthan, B.R.; Chandranayak, S.; Satish, S. Eggplant (Solanum melongena L.) associated endophytic bacteria promote plant growth and counter soil-borne plant pathogenic fungi. Authorea Prepr. 2023. [Google Scholar] [CrossRef]
- Chen, Y.; Li, A.; Feng, L.; Meng, Q.; Li, Y.; Zhang, D.; Liu, D.; Chi, G. Identification and colonization of an antagonistic endophytic bacterium L-4-2 against cotton verticillium wilt. J. Northwest Agric. Univ. 2012, 21, 68–71. [Google Scholar]

| Grape Varieties | Plant Tissue | Number of Strains/Strains | Strain Number |
|---|---|---|---|
| Vitis labrusca × vinifera ‘Kyoho | Seed | 5 | G30–G32, G34–G35 |
| Manicure Finger grapes | Old stems | 6 | G24–G29 |
| Vitis vinifera × V. labrusca ‘Boxin 1’ | Old stems | 12 | G13–G23, G36 |
| Vitis vinifera ‘Hongru’ | Old stems | 1 | G37 |
| Red Globe | Fruit | 12 | G1–G10, G33, G38 |
| Red Globe | Seed | 1 | G11 |
| Centennial Seedless | Fruit | 1 | G12 |
| Numbering | Incidence Rate/% | Inhibition Rate/% | Strain Number | Incidence Rate/% | Inhibition Rate/% |
|---|---|---|---|---|---|
| CK | 87.5 ± 2.9 lmnop | — | G19 | 60.8 ± 9.6 efghi | 30.5 ± 11.0 efgh |
| CN181 | 0.0 ± 0.0 a | 100.0 ± 0.0 a | G20 | 65.0 ± 10.1 fghij | 25.7 ± 11.5 fghij |
| G1 | 0.00 ± 0.00 a | 100.0 ± 0.0 a | G21 | 55.8 ± 15.0 defgh | 36.2 ± 17.2 defg |
| G2 | 46.7 ± 5.1 cdefg | 46.7 ± 5.8 cdef | G22 | 77.5 ± 5.8 io | 11.4 ± 6.6 hijklm |
| G3 | 4.2 ± 2.2 a | 95.2 ± 2.5 a | G23 | 44.2 ± 8.7 cde | 49.5 ± 9.9 cde |
| G4 | 1.7 ± 0.8 a | 98.1 ± 1.0 a | G24 | 61.7 ± 16.7 efghi | 29.5 ± 19.1 efghi |
| G5 | 0.0 ± 0.0 a | 100.0 ± 0.0 a | G25 | 59.2 ± 3.0 efghi | 32.4 ± 3.4 efgh |
| G6 | 7.5 ± 5.2 a | 91.4 ± 5.9 a | G26 | 45.8 ± 6.0 cdef | 47.6 ± 6.7 cdef |
| G7 | 5.8 ± 3.0 a | 93.3 ± 3.4 a | G27 | 76.7 ± 5.2 in | 12.4 ± 5.8 hijklm |
| G8 | 3.3 ± 2.2 a | 96.2 ± 2.5 a | G28 | 85.0 ± 3.8 klmnop | 2.9 ± 4.4 jklmn |
| G9 | 0.0 ± 0.0 a | 100.0 ± 0.0 a | G29 | 65.8 ± 15.2 ghik | 24.8 ± 17.3 fghij |
| G10 | 81.7 ± 0.8 jklmnop | 6.7 ± 1.0 ijklmn | G30 | 96.7 ± 0.8 op | −10.5 ± 1.0 mn |
| G11 | 68.3 ± 11.0 hil | 21.9 ± 12.6 ghijk | G31 | 86.7 ± 4.4 lmnop | 1.0 ± 5.0 klmn |
| G12 | 88.3 ± 6.7 mnop | −1.0 ± 7.6 klmn | G32 | 77.5 ± 2.9 io | 11.4 ± 3.3 hijklm |
| G13 | 94.2 ± 3.0 mnop | −7.6 ± 3.4 lmn | G33 | 1.7 ± 1.7 a | 98.1 ± 1.9 a |
| G14 | 75.8 ± 6.5 im | 13.3 ± 7.4 ghijkl | G34 | 100.0 ± 0.0 p | −14.3 ± 0.0 n |
| G15 | 37.5 ± 6.6 cd | 57.1 ± 7.6 bcd | G35 | 96.7 ± 3.3 op | −10.5 ± 3.4 mn |
| G16 | 34.2 ± 4.4 bc | 61.0 ± 5.0 bc | G36 | 98.3 ± 1.7 p | −12.4 ± 1.9 n |
| G17 | 60.0 ± 12.6 efghi | 31.4 ± 14.4 efgh | G37 | 95.8 ± 4.2 nop | −9.5 ± 4.8 lmn |
| G18 | 59.2 ± 11.6 efghi | 32.4 ± 13.2 efgh | G38 | 17.5 ± 10.9 ab | 80.0 ± 12.5 ab |
| Time/h | Germination Rate of Control/% | Germination Rate of Treatment/% | Inhibitory Rate/% |
|---|---|---|---|
| 2 | 6.40 ± 1.27 f | 3.15 ± 0.50 c | 50.78 |
| 4 | 28.01 ± 2.98 e | 4.71 ± 0.56 c | 83.18 |
| 6 | 52.61 ± 1.27 d | 5.65 ± 0.95 c | 89.26 |
| 8 | 71.97 ± 1.47 c | 20.34 ± 0.96 b | 71.74 |
| 10 | 86.01 ± 0.98 b | 33.67 ± 1.57 a | 60.85 |
| 12 | 91.96 ± 1.21 a | 32.35 ± 1.51 a | 64.82 |
| Sporangium | Point Sample | Morbidity | INCIDENCE/% | Inhibition Rate/% |
|---|---|---|---|---|
| Mixture of crude protein and sporangium suspension (1:1) | 120 | 20 | 16.7% | 70.8 |
| Sporangium of downy mildew | 120 | 105 | 87.5 |
Disclaimer/Publisher’s Note: The statements, opinions and data contained in all publications are solely those of the individual author(s) and contributor(s) and not of MDPI and/or the editor(s). MDPI and/or the editor(s) disclaim responsibility for any injury to people or property resulting from any ideas, methods, instructions or products referred to in the content. |
© 2024 by the authors. Licensee MDPI, Basel, Switzerland. This article is an open access article distributed under the terms and conditions of the Creative Commons Attribution (CC BY) license (https://creativecommons.org/licenses/by/4.0/).
Share and Cite
Qiao, W.; Kang, X.; Ma, X.; Ran, L.; Zhen, Z. New Strain of Bacillus amyloliquefaciens G1 as a Potential Downy Mildew Biocontrol Agent for Grape. Agronomy 2024, 14, 1532. https://doi.org/10.3390/agronomy14071532
Qiao W, Kang X, Ma X, Ran L, Zhen Z. New Strain of Bacillus amyloliquefaciens G1 as a Potential Downy Mildew Biocontrol Agent for Grape. Agronomy. 2024; 14(7):1532. https://doi.org/10.3390/agronomy14071532
Chicago/Turabian StyleQiao, Wenyan, Xingjiao Kang, Xiwei Ma, Longxian Ran, and Zhixian Zhen. 2024. "New Strain of Bacillus amyloliquefaciens G1 as a Potential Downy Mildew Biocontrol Agent for Grape" Agronomy 14, no. 7: 1532. https://doi.org/10.3390/agronomy14071532
APA StyleQiao, W., Kang, X., Ma, X., Ran, L., & Zhen, Z. (2024). New Strain of Bacillus amyloliquefaciens G1 as a Potential Downy Mildew Biocontrol Agent for Grape. Agronomy, 14(7), 1532. https://doi.org/10.3390/agronomy14071532
